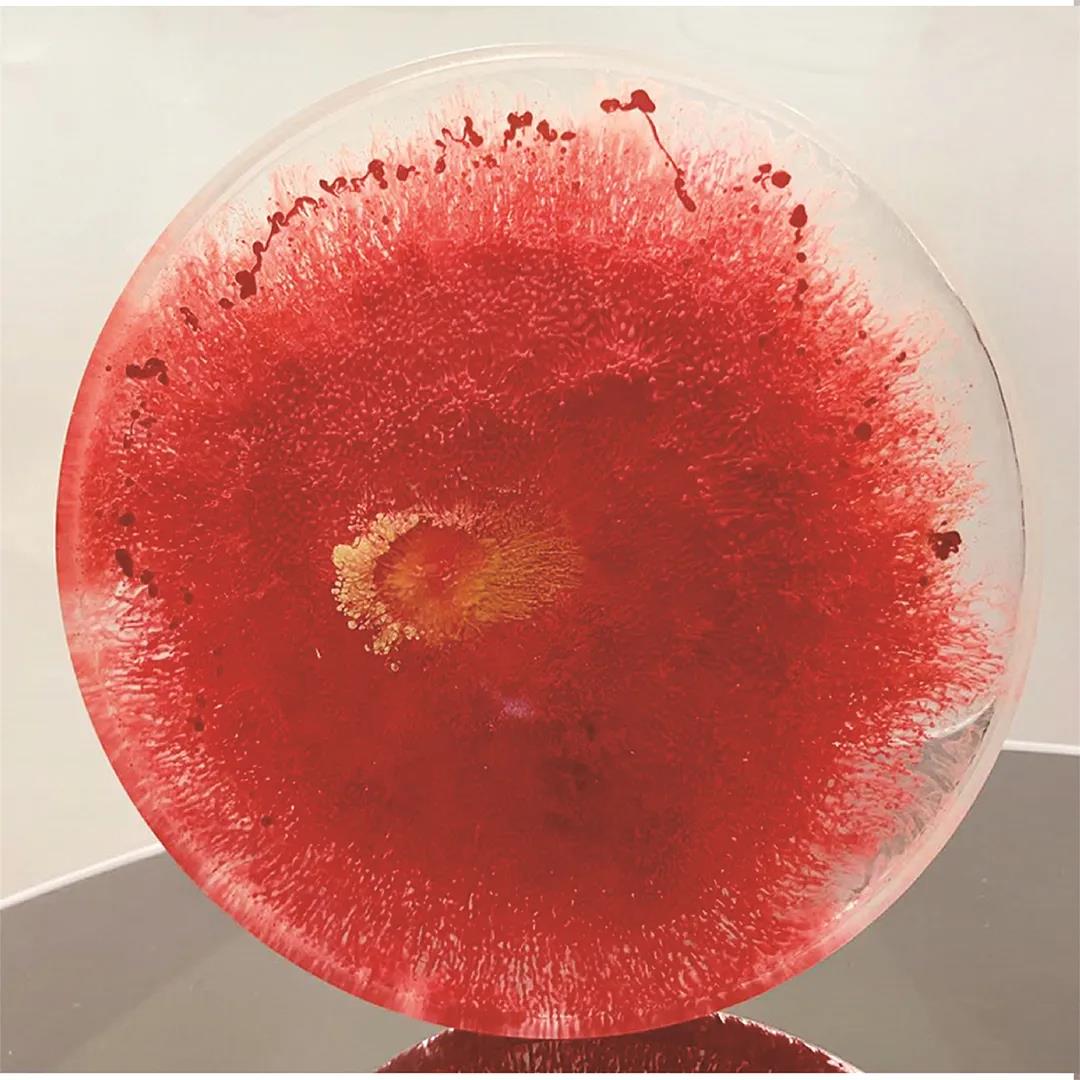
21.jpg 21.jpg

前言
有一种友谊叫朝夕相伴
有一种缘分叫师生情缘
有一种回忆叫西亚斯美
有一种离别叫不说再见
六月,花儿谢去芬芳
六月,迎来硕果飘香
六月,校园阳光灿烂
六月,我们拒绝忧伤
特别的毕业季,我们用心灵耕耘着网课
特别的艺设人,你们用创意勾画着蓝图
2020,爱你爱你
奔跑吧后浪!
“异星流浪”系列动态插画
作者姓名:石凤华
指导老师:贾艺丹
设计说明:“异星流浪”系列动态插画设计,整体风格属于“赛博朋克”风格,颜色多以红、蓝、紫等霓虹颜色为主,突显其科技感。每幅作品主要是通过想象来到外星所描绘的画面,贴合“异星流浪”的主题。画面通过局部和宏观的构图,给人一种外系星球上高度发达的科技文明,那里多数人身上都有辅助机械。城市霓虹闪烁,高楼林立。最后一幅看似温馨,行驶中中的交通工具,时不时有流星划过,周围环境虽然景色优美,但这里没有绿植,就连动物都是机械的样子,通过这样来表达外系星球就算再怎么发达也是冷冰冰的外表罢了。

< < 滑动查看下一张图片 >>
奈四儿卡通形象及衍生品设计
作者姓名:王子悦
指导老师:贾艺丹
设计说明:在当下这个高速发展的信息化时代,人们的交流方式也因社会模式的变化发生了改变。冰冷的屏幕两端传递着双方社交的讯息,失去了原始社交那种亲切的感觉。这也正是我做这项毕业课题的初衷,想打破冰冷屏幕的局限,设计出“奈四儿”这一可爱的卡通形象,通过“表情包”这一时代产物的形式表现出来,应用在平时的讯息传递中,为之增添一份人情味。“奈四儿”以赤狐为基础,夸张表现处理,突出其聪明伶俐、积极向上的性格。“表情包”的设定寓意贴近生活,真正做到为人所用。

< < 滑动查看下一张图片 >>
“绮梦”综合材料艺术品设计
作者姓名:王一丹
指导老师:金鑫
设计说明:本课题想要表达一种世间百态、难以捉摸,但美好总是永远存在的概念,就好似一场绚丽、美好的梦。通过描绘一些深海的场景,加上带有神秘色彩的人鱼形象,但围绕其中的深海生物并非都是漂亮友善的,而是面目凶猛、冷血无情的,用此情景来映射对当今人类世界的观点。作品在材料的使用方面,运用水彩颜料与较为新颖的珠光水彩颜料相结合,在此基础上再加以金箔、金粉、晶石等材料进行装饰,增加画面的质感与层次感。

< < 滑动查看下一张图片 >>
< < 滑动查看下一张图片 >>

“MOOD·S”食品包装设计及推广
作者姓名:王瑜琦
指导老师:景茹越
设计说明:本次课题选定为巧克力包装设计,主要是通过心情、口味、颜色为研究方向,将恋爱中产生的心情变化作为主要参考,以不同心情代表的颜色与巧克力口味结合,以插画的形式展现包装设计的画面。“MOOD·S”巧克力品牌以恋爱为主题,保持着巧克力作为爱情礼物的特点和浪漫,带给人们甜蜜快乐的品牌联想,作为表达爱情的礼物。此次包装设计考虑消费者的需求,不论是自己享用还是作为礼物赠送他人,将生活中情感化的事物应用在包装上,让巧克力的包装与日常生活建立连接,使包装设计赋予新的意义。这次设计以心情为切入点,划分为一周恋爱心情,将包装分为七种口味及颜色,每一种口味都有属于自己的恋爱心情。
“怪物家族”校园生活品牌形象设计
作者姓名:张帅
指导老师:梁金明
设计说明:“怪物家族:校园生活品牌形象设计是以家族式策略为起点进行的品牌设计。打破传统校园服务类品牌的发展舒适区,创新品牌形式,拉近与大学内的群体的距离。针对五种基础功能服务进行了不同的吉祥物形象设计,将每一个形象与服务相适应,且各具特色和特色,增强品牌的识别度。将校园内的所需功能整合化设计,使得服务更高效。五个形象代表了一个团结、友爱、青春、活力的大家庭,同时也能引起广大学生群体的共鸣。
< < 滑动查看下一张图片 >>
< < 滑动查看下一张图片 >>
< < 滑动查看下一张图片 >>
“岁月如梭”主题插画设计
作者姓名:黄革瑾
指导老师:梁金明
设计说明:“岁月如梭”主题插画设计,利用绘画艺术与独特的插画设计表现形式相结合,采用色彩与图形巧妙结合的表现手法,创造出独特而鲜明的主题插画,从呈现出丰富的视觉效果。“岁月如梭”主题插画设计,从生活的不同角度出发, 对一个人一生的每个阶段所进行设计。希望在快节奏生活的今天,通过这组插画能够让人们在和时间赛跑的同时,发现来自日常生活中的乐趣与美好。
< < 滑动查看下一张图片 >>
“万物生”海洋文化创意设计
作者姓名:文杰
指导老师:刘丹丹
设计说明:本次毕业设计课题是海洋文化创意设计,以海洋元素插画创作为表现形式,以直观的视觉画面表现海洋内部的生物、生态、地貌特征。通过系列作品的视觉信息传达,描绘了海洋千奇百怪的地貌,美轮美奂的海洋景象,物种丰富的海洋生态,令人感受到海洋生命的活力,以此来激发人类对于海洋的内心感触,对自然生命的敬畏,期望人类反思自我,保护海洋自然生态,达到“人人生、万物生”的美好愿景。
< < 滑动查看下一张图片 >>
< < 滑动查看下一张图片 >>
< < 滑动查看下一张图片 >>
2020毕业设计|“嘿!别学我!”
儿童绘本设计
作者姓名:丁淑娟
指导老师:刘丹丹
设计说明:“嘿!别学我!”儿童绘本设计,从儿童的生活入手,以家长比较重视的儿童危险行为、儿童日常饮食、儿童行为习惯等四个方面来让孩子们了解生活中所存在的安全隐患、危险行为习惯与不良饮食习惯所带来的危害,使孩子们在阅读时联想到自己的行为从而引起共鸣。孩子们通过对“嘿!别学我!”儿童系列绘本的阅读,增强安全意识、养成良好的生活习惯、饮食习惯。
< < 滑动查看下一张图片 >>
< < 滑动查看下一张图片 >>
< < 滑动查看下一张图片 >>
“崇·重”民间艺术创新设计
作者姓名:王晓艺
指导老师:刘丹丹
设计说明:毕业设计立足于民间艺术,以虎头鞋图案的设计与创意表现为主,虎头鞋通过栩栩如生的图案造型与明快艳丽的色彩形成了民间美术特有的艺术美感。设计从虎头鞋的图案、形状、颜色、工艺等方面获得灵感,提取元素,归纳总结,重新塑造了它们的形态特征,并结合当代的设计技术和理念进行创新,赋予虎头鞋新的使命感和传播力,使这一珍贵的民间手工艺术得以广泛的保护和传承发展。
< < 滑动查看下一张图片 >>
《所爱隔山海》
作者姓名:宋弘鹏
指导老师:鲁珂
设计说明:“所爱隔山海”创意插画设计的主要灵感来自于山海经异兽录,通过与现代生活的结合介绍了山海经中部分奇珍异兽的特征和生活习性;用国潮和graffiti两种风格的结合,将现代插画艺术与传统文化相融合,给予每一个奇珍异兽现代身份,将其融入现代社会,展现出一个不一样的山海经异兽录,我希望通过我的作品可以引领更多的人关注和喜欢我们的中华传统文化。
< < 滑动查看下一张图片 >>
< < 滑动查看下一张图片 >>
“风动敦煌”创意插画设计
作者姓名:杨丽萍
指导老师:鲁珂
设计说明:“风动敦煌“创意插画设计主要取源于敦煌艺术文化。本设计选定了五个敦煌故事作为插画的创作导向以及中心主题。分别是九色鹿、尸毗王割肉喂鹰、夜半逾城、乘象入胎、飞天。每幅插画的画面结构、元素搭配、人物形象角色、以及画面配色和元素的添加都是围绕每个故事的情节内容。在本次设计中,主要将现代插画风格与传统艺术进行结合,创作出既具现代感又含有传统文化的现代插画。既保留了传统艺术文化的价值又实现了现代插画的再次创新。

< < 滑动查看下一张图片 >>
< < 滑动查看下一张图片 >>
《中文字库字体开发与研究》——润刻体
作者姓名:王世莹
指导老师:陶宗晓
设计说明:该作品是以魏碑书法的特点和风格为基础,融入现代字体的设计手法设计出的一款字体。让传统魏碑汉字艺术以字库的形态重新展现在大家的视野中。字体字形为扁方形,中正大方,标点符号也融入了魏碑的特点。该字体为标题字体,可以广泛应用在招牌、广告、包装、书籍等载体。

< < 滑动查看下一张图片 >>
< < 滑动查看下一张图片 >>
海子诗文系列书籍设计
作者姓名:周迪
指导教师:陶宗晓
设计说明:我用“死者看不开,生者看不见”来描述《九月》这首歌。诗人海子,原名查海生,是一位当代先锋诗人的代表, 他的诗是一种明亮又纯粹的存在,就像书籍的主题色,与环境色在视觉对比上有着强烈冲突,又格外能体现出自我存在意识的克莱因蓝。书籍设计的方方面面都有尝试可言,而作为一名设计者,在实践中学习它所包含的艺术思维、构思创意和技术手法的系统与整体运用,是我的一次有幸经历。
< < 滑动查看下一张图片 >>

“大美四川”文创设计
作者姓名:岳文彤
指导老师:王琼
设计说明:“大美四川”文创产品设计从插画的角度增强文创产品的文化底蕴,将地域文化元素用独特的设计手法融入插画中,再利用插画元素进行文创产品应用。插画以熊猫在四川游山玩水为创意点,分别与四川的火锅、茶、麻将、川剧和宽窄巷子等元素相结合,赋予故事性。使用不寻常的比例和组合来表现创新性和独特性,使文创产品变得更加引人注目。

“童年时光机”包装整体形象设计
作者姓名:辛姝贤
指导老师:王琼
设计说明:“童年时光机”围绕童年玩具展开设计,童年是每一个人所具有的最美好的回忆,也是最难以忘怀的一种记忆,本课题运用一种“思维穿越”的模式进行设计,选择从80、90后有关童年的记忆中的玩具主题出发,并从玩具本身提取元素进行包装插画设计,“以新包旧”,通过生动、活泼的图形展现玩具包装整体形象。
< < 滑动查看下一张图片 >>

“浮跃而出”瓦当图形演绎设计
作者姓名:王倩影
指导老师:王琼
设计说明:中国瓦当文化历史悠久, 既具有实用性又具有装饰性,瓦当图形更是丰富多样,构思巧妙。“浮跃而出”瓦当图形演绎设计就是从众多瓦当图形中取材,突破原有的瓦当圆形形制,让瓦当中的图形“浮跃而出”,将瓦当图形元素平面化并结合现代设计手法,重新打乱设计并赋彩,用和谐的色彩来营造出律动感,用多样展示形式来增添趣味性,为大家带来全新的瓦当图形面貌。

< < 滑动查看下一张图片 >>
< < 滑动查看下一张图片 >>
“机械迷城”装饰艺术设计
作者姓名:杨金睿
指导老师:严西育
设计说明:社会经济的发展,带动了资源的消耗,当地球能源匮乏时,工作的压力、疫情的危机和不同国家社会阶级的不平等性,加大了人们面对生活的乏味,也加重了环境污染的可能。我的作品以“机械迷城”装饰艺术为切入点,名字的前身源自一款解谜游戏,机器的背景加上末日的启迪,以及机器人为了与同类斗志斗勇戴上了装有电灯的帽子。作品水管灯乐队主要针对低碳环保为启示,以唤醒人们回归生活的热情为目标,为人类命运共同体而思考。
< < 滑动查看下一张图片 >>

“神傩秘界”图形及衍生品设计
作者姓名:张倩
指导老师:严西育
设计说明:傩,是一种古老的而神秘的原始祭祀用礼。神傩秘界设计旨在通过设计唤醒人们对传统文化的重视,传统文化不仅仅需要国家的保护,同时也需要我们根据传统文化的特征让其在新时代有用武之地,服务于大众,才更能展现其神秘莫测,悠久绵长的文化传承。在进行神傩秘界的图形设计时,我将颜色和图形符号的运用作为创新的主要方面,另外还将图形代表的符号特征运用到整个的设计当中,力求设计的和谐统一。让传统文化焕发生机和活力同时也是新时代对于文创产品开发的要求,因而更具时代性,更具说服力。
< < 滑动查看下一张图片 >>
“戏·传呈 ”文创设计
作者姓名:王思蔚
指导老师:严西育
设计说明:2020年是鼠年,属相也属于文创的一种,中国戏曲源远流长,种类丰富,利用戏曲中的生旦净末丑与鼠相相结合,创新的方式,设计出为中国传统文化增添色彩,为戏曲文化与文创产品设计的结合提供思路和方案,为戏曲文化的传承提供土壤。统一主色调,分为红蓝黄绿,更能表现整体统一的效果使设计完整,以其中一个人物形象围绕展开进行延伸,制作了很多Q版萌态的卡通形象,在此次设计中所采取的插画风格则较为童真简约,通过色彩的搭配、统一的手法以及情感色彩的融入进行设计主体的表达,最终所呈现出的画面是丰富且拥有亲切感的。
< < 滑动查看下一张图片 >>
“源”——视觉图像创新表达
作者姓名:韩思全
指导老师:周小丹
设计说明:当今社会,随着人们的生活水平不断提高,艺术家的眼界也逐渐提高,对绘画材料的要求也变得丰富多样。所以我此次设计就从创新型材料的图像表达为出发点进行创作,此次作品选用了树脂材料进行绘画。绘画作品不同于以往树脂画的写实风格,采用了抽象图形进行课题“源”的表达,本课题设计的目的是通过“源”一系列的树脂画,让观者更全面了解树脂画,同时希望观者能对图像创新表达和树脂画有新的认识。
< < 滑动查看下一张图片 >>
“浩瀚星球”纤维艺术创意设计
作者姓名:胡永康
指导老师:李焕秋
设计说明:本设计是纤维艺术设计,作品的主要元素为光,利用光纤和金属球内置发光装置和泡沫球组成,整体作品可以调整多种灯光,能够和光闪着进行互动,每种光的组合都能够带给观赏者不同的艺术享受,具有多种变化,多样的艺术氛围。在本次设计中也遇到了许多问题,从最初的草图整体设想,再到后面的材料制作和整体组装过程,都遇到了一些困难,但是在查阅相关资料和请教老师后问题都得到了解决,经过这次毕业设计,我学到了许多新的知识,并且动手能力也获得了提高,提升了设计水平,使我受益匪浅。

< < 滑动查看下一张图片 >>